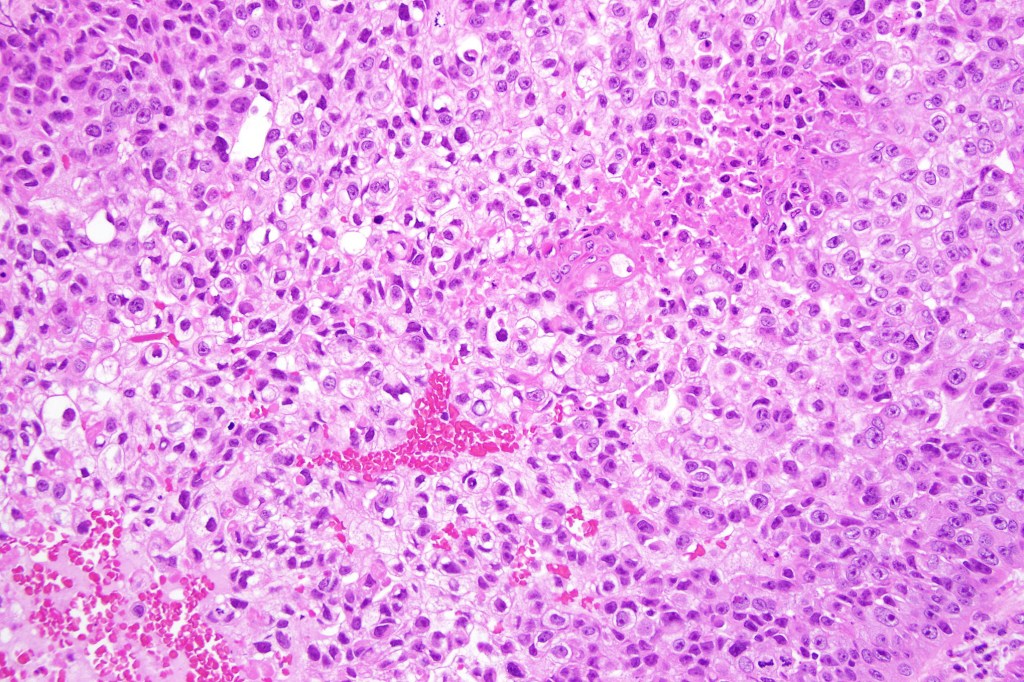

Clinical features
•Rare variant
•Sun-damaged skin of the head & neck
•M>>F
Histological features
•Clear cell change results from cytoplasmic glycogen accumulation
•Can be focal or involve most of the tumor
•Exceptionally, this can present with a signet ring-like appearance

Differential diagnosis
If obvious squamous differentiation is not apparent, then metastatic clear cell carcinoma is an important differential diagnosis. Clear cell change may also be seen in a wide range of tumors including basal cell carcinoma, trichilemmal carcinoma, clear cell hidradenocarcinoma, porocarcinoma & melanoma. These are all discussed in respective blogs.
Leave a comment